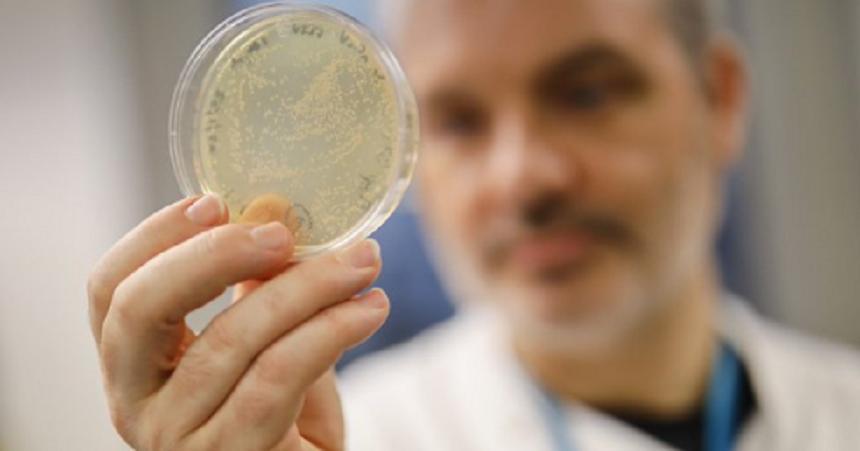
Industria farmaceutică promite un vaccin &icirc;mpotriva covid-19 &icirc;n 12-18 luni

Social
Urmareste stirile sociale de ultima ora si fii la curent cu tot ce se intampla. Fii informat cu A1: ziar online cu ultimele stiri de la surse de incredere.

Pandemia nu-i sperie pe tineri. Peste 100 de împătimiţi de curse ilegale s-au strâns în parcarea din faţa Casei Poporului
România nu conştientizează nicio secundă cât de important este să rămânem în casă. Numai seara trecută, peste o suta de oameni s-au adunat în parcarea din față Casei Poporului. Cu maşinile sau cu motocicletele, încărcaţi cu multă adrenalină, cu toţii erau pregătiţi pentru cursele ilegale. Distracţia a fost însă stricată de oamenii legii.
Sambata, 21.03.2020, 10:48
Decizie drastică! Într-un oraș din România grupurile mai mari de trei persoane nu au voie să staționeze pe stradă
O interdicție excepțională a fost introdusă într-un oraș din România! Grupuri mai mari de trei persoane nu au voie să staționeze pe stradă.
Sambata, 21.03.2020, 10:32
Ghid de bune practici la cumpărături: Reguli pe care trebuie să le respectăm și cât/ce mâncăm în carantină
Ghid de bune practici la cumpărături! Supermarketurile sunt în aceste zile singurele locuri în care ne mai întâlnim. Astfel că avem nevoie de un ghid de bună purtare pentru a ne proteja pe noi şi pe ceilalţi.
Sambata, 21.03.2020, 09:44
Unui bărbat izolat la domiciliu i-a luat foc casa. Pompierii care au intervenit au fost carantinați imediat
Situaţie atipică în contextul izolării la domiciliu. Un bărbat din comuna Oşeşti, judeţul Vaslui, care s-a întors din Italia pe 8 Martie şi ar mai fi avut doar două zile de autoizolare, a rămas pe drumuri.
Sambata, 21.03.2020, 09:25
Nimeni pe străzi și Bucureștiul poluat cu peste 300%. "Nu se poate respira!" Valorile înspăimântătoare înregistrate vineri seara au alarmat oamenii
Grad ridicat de poluare înregistrat în Bucureşti, noaptea trecută. Deşi pare că în această perioada Capitala se odihneşte şi aerul e mai curat, iar nu demult ministrul Mediului, Costel Alexe, anunţa că bucureştenii respiră acum "aer de munte", valorile au crescut masiv, dintr-odată.
Sambata, 21.03.2020, 09:08
1.500 de români repatriați din Italia au intrat în România. Vor sta în carantină departe de casele lor. Președintele CJ Constanța: "E un caz de iresponsabilitate maximă."
Situaţie tensionată în Constanţa acolo unde vor ajunge aproape 1.500 de români, repatraiţi din Italia, din zone afectate de coronavirus. Oamenii erau angajaţi acolo sezinier. Vor ajunge în ţară cu mai multe curse aeriene speciale după ce Ministerul Afacerilor Externe a anunţat că a identificat mai multe variante de transport, în perfectă siguranţă.
Sambata, 21.03.2020, 08:56
11.129 de persoane din în întreaga lume au murit din cauza coronavirusului
Noul coronavirus a dus la moartea a 11.129 de persoane în întreaga lume de la apariţia sa în decembrie, potrivit unui bilanţ al AFP, bazat pe surse oficiale şi transmis vineri seară.
Sambata, 21.03.2020, 07:58Valentin este asistent medical în Milano și zilnic ia contact cu pacienți: „Nu știm ce găsim! Poate fi o familie care s-a infectat"
La 38 de ani, Valentin s-a stabilit în Italia. Este asistent medical la Milano și tratează pacienți la domiciliu, pentru a nu fi și mai aglomerate spitalele din Peninsulă. Este trimis la un caz, însă nu știe unde va ajunge și nici dacă va mai pleca sănătos de acolo.
Vineri, 20.03.2020, 23:20Care este schema de tratament folosită la bolnavii cu Covid-19. Dr. Virgil Musta: "Fiecare medicament are și efecte toxice"
Dr. Virgil Musta, medic primar boli infecţioase la Spitalul „Victor Babeș” din Timișoara, a vorbit la Antena 3 despre schema de tratament folosită la bolnavii cu COVID - 19.
Vineri, 20.03.2020, 22:50
Alertă în Călărași! O persoană întoarsă din Anglia nu a respectat izolarea la domiciliu. Ulterior, a fost confirmată cu Covid-19
O persoană revenită din Marea Britanie, în judeţul Călăraşi, este cercetat penal pentru că nu a respectat izolarea la domiciliu, bărbatul mergând la sediul unei societăţi comerciale, unde s-a întâlnit cu cel puţin cinci persoane. Ulterior, el a fost testat pentru coronavirus, fiind infectat cu Covid-19.
Vineri, 20.03.2020, 22:35
„Se va ajunge la un milion de șomeri”. Președintele Camerei de Comerț și Industrie a României, despre efectele crizei declanașate de coronavirus
Mihai Daraban, președintele Camerei de Comerț și Industrie a României, a declarat vineri, la Antena 3, că s-ar putea ajunge la un milion de șomeri, până la sfârșitul crizei declanșate de pandemia de coronavirus.
Vineri, 20.03.2020, 21:44
Ana Maria și Alex au luat coronavirus din vacanță: "Luați în serios pandemia. Nu e de glumă, trăim pe pielea noastră!"
Ana Maria și Alex sunt doi tineri din Mangalia. El a fost depistat pozitiv cu coronavirus. Ea încă așteaptă rezultatul testului Covid-19. Cei doi au fost plecați în vacanță, iar la întoarcerea în țară s-au izolat. După câteva zile, Alex s-a simțit foarte rău și a mers la spital. Virusul s-a confirmat. Postarea Anei pe Facebook trage un semnal de alarmă pentru toți cei care cred că nu pot păți nimic.
Vineri, 20.03.2020, 21:15
Ce se întâmplă cu pensiile, salariile și ajutoarele de șomaj, în perioada următoare? Florin Cîțu, ministrul Finanțelor, declarații exclusive, la Observator
Minsitrul Finanțelor, Florin Cîțu, precizări importante despre plata salariilor, pensiilor, ajutoarelor sociale și despre acordarea certificatului de situație de urgență.
Vineri, 20.03.2020, 20:35
Oficial, nu doar vârstnicii sunt în pericol! Avertisment dur lansat de șeful OMS: "Tinerilor, nu sunteți invincibili în fața Covid-19!"
Coronavirusul nu afectează doar bătrânii, ci și pe cei tineri, iar asta trebuie să fie un semnal de alarmă pentru cei care cred că vârsta îi va proteja de coronavirus. Un avertisment dur a fost lansat de șeful Organizației Mondiale a Sănătății (OMS), care susține că aceșția trebuie să ia în serios amenințarea Covid-19.
Vineri, 20.03.2020, 20:20
Scenariu de limitare drastică a circulației. Profesorul Adrian Streinu Cercel, declarații în exclusivitate: "Suntem destul de aproape de acest lucru"
Afară din casă, doar cu bilet de voie. Pentru câteva ore, acest scenariu părea o chestiune care se va întâmpla imediat şi în Romania. Totul din pricina unui document care arata ca o Hotărâre de Guvern şi care introducea restricţii de circulaţie. Autoritățile au infirmat decizia, explicând că este vorba doar de o propunere. Profesorul Adrian Streinu Cercel susține, însă, că România nu este departe de acest scenariu.
Vineri, 20.03.2020, 19:32
Medicii de familie riscă să devină victime ale Covid19: "Nu avem resursele de autoprotecţie şi dezinfecţie"
Societatea Naţională de Medicina Familiei / Medicină Generală atrage atenţia autorităţilor că medicii de familie se confruntă cu riscul de a deveni "victime sau potenţiale surse de infecţie" cu coronavirus, întrucât vor prelua mai multe responsabilităţi, dar tehnic nu sunt pregătiţi, neavând echipamente de protecţie şi dezinfectanţi.
Vineri, 20.03.2020, 18:42
Cât de repede poți afla că ești pozitiv? România va avea un aparat de testare rapidă a persoanelor suspecte de coronavirus
Un aparat în valoare de 300.000 de lei a fost achiziționat, prin intermediul Ministerului Sănătății, de Direcția de Sănătate Publică din Buzău. Aparatura are capacitatea de testare rapidă a persoanelor suspecte de îmbolnavire cu noul coronavirus.
Vineri, 20.03.2020, 18:11
Un vaccin experimental împotriva coronavirusului va fi adus în România. Anunțul făcut de Streinu-Cercel: „Într-o lună vom avea documentele”
Un vaccin experimental împotriva coronavirusului, testat în Marea Britanie, va ajunge în România. Este anunțul făcut de profesorul Adrian Streinu-Cercel, directorul Institutului de Boli Infecţioase Matei Balş
Vineri, 20.03.2020, 18:05
Coronavirus în România, măsuri extreme! Medicul Adrian Streinu-Cercel: "Se va limita mersul pe stradă"
România a luat măsuri extreme pentru a împiedica răspândirea noului tip de coronavirus. În contextul declarării stării de urgență în țara noastră, restaurantele și cafenelele au fost închise, iar autoritățile au recomandat populației să stea acasă pe cât posibil.
Vineri, 20.03.2020, 18:04
Aveți grijă ce măști folosiți pentru a vă proteja de coronavirus! Avertismentul OMS: „Nu ajută la nimic”
Avem în continuare un avertisment venit din partea Organizaţiei Mondiale a Sănătăţii. Măstile fabricate manual din pânză, bumbac sau tifon NU protejează împotriva infecţiei cu noul coronavirus.
Vineri, 20.03.2020, 17:43
Trei români au murit în afara granițelor din cauza coronavirusului. Alte 29 de persoane sunt infectate în alte țări
Vești proaste vin din afara granițelor, întrucât trei români, între care femeia care tocmai a fost înmormântată în Maramureș, au murit din cauza coronavirusului.
Vineri, 20.03.2020, 15:45
Bărbat audiat de poliţiştii din Capitală după ce ar fi scuipat, în trafic, o persoană aflată într-o maşină
Un bărbat este audiat, vineri după-amiază, de poliţiştii de la Secţia 21 din Bucureşti după ce ar fi scuipat, în trafic, o persoană aflată într-o maşină, prin geamul deschis.
Vineri, 20.03.2020, 15:34
O clinică privată din România testează populația pentru coronavirus, contra cost
O clinică privată din România a anunțat că testează populația, la cerere, pentru coronavirus.
Vineri, 20.03.2020, 15:23
Firea a trimis scrisori către cinci ambasade, printre care cele ale SUA, Germaniei şi Chinei, pentru a solicita sprijin pentru cele 19 spitale din Bucureşti
Primarul municipiului Bucureşti, Gabriela Firea, a anunţat că a trimis scrisori către ambasadele SUA, Germaniei, Chinei, Israelului şi Austriei pentru a fi trimise capitalelor statelor respective, în vederea solicitării unui sprijin pentru cele 19 spitale din Bucureşti. Firea a precizat că a luat această decizie deoarece în Capitală sunt cele mai multe cazuri confirmate de Covid-19, din întreaga ţară, dar şi de persoane aflate în carantină.
Vineri, 20.03.2020, 15:02
Ce se întâmplă cu pensiile și salariile românilor. Ministrul Finanțelor, anunț de ultimă oră: ”Nu lăsăm pe nimeni în urmă!”
Starea de urgență din România instalată din cauza coronavirusului nu va afecta plata salariilor și a pensiilor, potrivit anunțului făcut de ministrul Florin Cîțu.
Vineri, 20.03.2020, 14:59
Administratorul unei cafenele, amendă uriașă după ce a refuzat să suspende activitatea. Poliția anunță controale severe în următoarele zile
Deși au trecut câteva zile de când autoritățile au decis ca restaurantele, barurile și saloanele de înfrumusețare să fie închise, administratorul unei cafenele a ignorat această lege și nu a suspendat activitatea.
Vineri, 20.03.2020, 14:57
Doi bărbaţi au fost reţinuţi de procurorii DIICOT Galaţi pentru trafic de droguri, după ce au vândut cannabis şi ecstasy
Doi bărbaţi au fost reţinuţi de procurorii DIICOT Galaţi, ei fiind suspectaţi că din toamna anului trecut şi până în prezent au vândut cannabis şi ecstasy către diverşi consumatori din judeţ.
Vineri, 20.03.2020, 14:32
Un poliţist de frontieră din Mehedinţi s-a împuşcat mortal în cap cu arma din dotare
Un poliţist de frontieră din judeţul Mehedinţi, în vârstă de 39 de ani, s-a împuşcat în cap cu arma din dotare, fiind găsit de colega sa de patrulă fără semne vitale. Bărbatul se afla la locul de muncă, la Sectorul Poliţiei de Frontieră Porţile de Fier II.
Vineri, 20.03.2020, 14:06
Primele imagini de la spitalul mobil care este construit lângă București. În cinci zile, aici vor putea fi tratați pacienții infectați cu coronavirus!
Numărul persoanelor infectate cu noul coronavirus a ajuns la 308, iar autoritățile se pregătesc de ce e mai rău, motiv pentru care au început construirea unui spital militar după standarde NATO.
Vineri, 20.03.2020, 14:06
Sfaturi de sănătate: Ce și cât mâncăm în izolare
Ne-am izolat şi aprovizionat. Ne-am umplut mai mult sau mai puţin cămara şi frigiderul cu tot felul de alimente. Şi am limitat mişcarea, nu prea avem de ales. Prin urmare, nu mai consumăm la fel de multe calorii.
Vineri, 20.03.2020, 13:53
Primăria Sectorului 4 a creat o unitate specială pentru dezinfectarea spaţiilor publice, care va lucra non-stop
Primăria Sectorului 4 are la dispoziţie, începând de vineri, o unitate specială pentru spălarea şi dezinfectarea spaţiilor publice, care va lucra non-stop, în ture, urmând să cureţe şi să igienizeze toate arterele, trotuarele, aleile de intrare în bloc, scările de bloc, spaţiile de joacă şi locurile de relaxare.
Vineri, 20.03.2020, 13:41
Adio minivacanţă de 1 Mai! Restricțiile impuse în această perioadă de criză blochează operatorii turistici
Adio minivacanţă de 1 Mai, distracţie în Vamă şi nopţi petrecute în cluburi. Operatorii turistici de la malul Mării Negre se confruntă deja cu un blocaj economic din pricina restricţiilor impuse după răspândirea coronavirusului.
Vineri, 20.03.2020, 13:32
Nereguli descoperite la Spitalul din Filiași. Procurorii au deschis dosar penal
Procurorii din Filiaşi au deschis un dosar penal pentru abuz în serviciu şi zădărnicirea combaterii bolilor după ce, în perioada 15-19 martie, membri ai conducerii spitalului din localitate şi-au îndeplinit defectuos atribuţiile de serviciu, iar ca urmare un pacient a răspândit infecţia cu coronavirus.
Vineri, 20.03.2020, 13:24
Anunț OMS: Măștile fabricate manual sau din pânză/bumbac/tifon NU protejează împotriva infecției cu coronavirus
Multe fabrici pentru a nu-și sista activiattea, în scopul de a ajuta, au început să fabrice măști din materiale textile cu scopul protecției. Însă Ministerul Sănătății citează OMS și instituții internaționale de sănătate atrăgând atebția asupra faptului că măștile fabricate manual sau din pânză/bumbac/tifon NU protejează împotriva infecției cu coronavirus.
Vineri, 20.03.2020, 13:20
Alte 31 de cazuri de infectare cu coronavirus / Numărul total al îmbolnăvirilor a ajuns la 308
Alte 31 de cazuri de infectare cu coronavirus au fost înregistrate de la ultima raportare, astfel că numărul total al îmbolnăvirilor a ajuns la 308.
Vineri, 20.03.2020, 13:01
Medicul estetician Adina Alberts își pune la dispoziție, GRATUIT, spitalul pentru bolnavii de COVID 19: "Pun pentru cetățeni, atât unitatea spitalicească pe care o conduc, cât și experiența mea în medicină. Total gratuit!"
Cu România în stare de urgență pe tema coronavirusului, autoritățile au început să caute soluții pentru a identifica spații pe care să le poată folosi atât pentru tratarea persoanelor infectate, cât și pentru cazarea celor care trebuie să stea în carantină pentru o perioadă de două săptămâni.
Vineri, 20.03.2020, 12:43
Industria farmaceutică promite un vaccin împotriva covid-19 în 12-18 luni
Multinaţinale din industria farmaceutică s-au angajat să furnizeze un vaccin împotriva bolii covid-19 ”în toată lumea” în 12 până la 18 luni, relatează AFP.
Vineri, 20.03.2020, 12:38
Cel mai mare mall din România, Băneasa Shopping City, se închide voluntar în perioada 23 martie – 16 aprilie 2020 pentru a proteja clienții și angajații
Oficialii mallului adaugă că Băneasa Shopping City consideră că este de datoria sa să protejeze comunitatea, clienţii, retailerii precum şi angajaţii care îşi desfăşoară activitatea de zi cu zi în magazinele centrului comercial, pentru că sănătatea şi siguranţa lor sunt o prioritate permanentă.
Vineri, 20.03.2020, 12:26
Studenţii la Medicină din Bucureşti se implică în criza coronavirusului
Studenţii la Medicină din Bucureşti se implică în criza coronavirusului si vin cu soluţii inovatoare.
Vineri, 20.03.2020, 12:14
Documentul potrivit căruia s-ar interzice deplasările este o "Scurgere de informații". Grupul de Comunicare Strategică face precizări: " NU este un document aprobat"
Documentul a fost preluat în mediul online și distribuit la scară largă ca fiind o informație deja aprobată. O astfel de infromație poate produce mișcări majore în rândul populației, astfel gravitatea actului de divulgare a unor informații private nedestinate publicului și în stare de prelucrare este din ce în ce mai mare.
Vineri, 20.03.2020, 11:57
Două containere cu deşeuri, expediate din Australia, descoperite în Portul Constanţa Sud - Agigea
Două containere în care se găseau deşeuri, expediate din Australia, au fost descoperite în Portul Constanţa Sud - Agigea. Conform documentelor vamale, în cele două containere s-ar fi aflat anvelope uzate pentru autoturisme.
Vineri, 20.03.2020, 11:53
Garda Forestieră Timişoara a găsit 85 de cioate de arbori tăiaţi fără drept, prejudiciu de 33.112 lei. Pădurarul din cantonul silvic Valea Lungă este cercetat, pentru acesta s-a dispus măsura de arest la domiciliu
Garda Forestieră Timişoara a informat Ministerul Mediului Apelor şi Pădurilor că, la solicitarea Poliţiei Municipiului Brad, a făcut un control parţial în fondul forestier proprietate publică a statului român, administrat de Ocolul Silvic Brad, arondat cantonului silvic Valea Lungă, iar în urma acestui control, Garda Forestieră Timişoara a inventariat un număr de 85 de cioate de arbori tăiaţi fără drept, de diferite esenţe, volumul total al lemnului fiind de 52,127 metri cubi, iar valoarea prejudiciului de 33.112 lei.
Vineri, 20.03.2020, 11:45
STS: Peste 12.000 de apeluri referitoare la coronavirus făcute la 112, în foarte multe cazuri fără urgenţe reale / Unii au întrebat despre mersul trenurilor sau dacă pot chema zugravii pe timpul stării de urgenţă
Peste 12.000 de apeluri referitoare la coronavirus au fost făcute, în perioada 25 februarie - 18 martie, la numărul unic de urgenţă 112, reprezentanţii STS precizând că, în foarte multe cazuri, oameni au sunat pentru informaţii, fără a avea urgenţe reale. Printre întrebările primite de operatorii STS au fost unele referitoare la mersul trenurilor, programul Poştei sau al băncilor, dar şi privind "învoirea" din izolarea la domiciliu, lipsa mâncării pentru pisică sau dacă o persoană are voie să cheme zugravii, în timpul stării de urgenţă.
Vineri, 20.03.2020, 11:30
Raed Arafat, prima reacție după apariția documentul care prevede limitarea deplasărilor: ”Măsurile au caracter preventiv!”
Raed Arafat a reacționat imediat după ce a apărut în presă documentul pregătit pentru a limita deplasările. Astfel, secretarul de stat a declarat că documentul nu a fost aprobat, este unul destinat analizei de lucru din cadrul Comitetului Național pentru Situații Speciale (CNSSU) de Urgență.
Vineri, 20.03.2020, 11:28
ActiveWatch: Prin lipsa de transparenţă, instituţiile statului alimentează conspirationismul şi dezinformarea. Nu abandonaţi fundamentele democraţiei!
ActiveWatch a avertizat vineri autorităţile că renunţarea la comunicarea publică pentru rezolvarea problemelor crizei de coronavirus este o eroare gravă care poate să producă efecte contrare aşteptărilor.
Vineri, 20.03.2020, 11:27
Stare de urgență în România: Autoritățile, plângere penală după răspândirea documentului care anunță limitarea deplasărilor
Coronavirus în România - stare de urgență. Grupul de Comunicare Strategică a venit cu precizări oficiale, după ce un document care anunță limitarea desplasărilor în România s-a viralizat în timp record.
Vineri, 20.03.2020, 11:25Document privind restricţionarea deplasărilor în afara domiciliului, apărut în spaţiul public. Grupul de Comunicare Strategică spune că este un document de lucru, neaprobat şi că IGPR a sesizat DIICOT
Un document al Grupului de suport tehnico-ştiinţific privind gestionarea bolilor înalt contagioase pe teritoriul României,privind restricţionarea deplasărilor în afara domiciliului, datat 20 martie, a fost lansat vineri în spaţiul public, Grupul de Comunicare Strategică precizând că este vorba despre un document de lucru, aflat în analiză, neaprobat, iar măsurile conţinute în document nu au aplicabilitate imediată. Grupul de Comunicare Strategică anunţă că a fost sesizat DIICOT pentru infracţiunea de divulgare fără drept a unor informaţii care nu sunt destinate publicităţii.
Vineri, 20.03.2020, 11:20
Observator Update, 20 martie, ora 11:00: Peste 10 mii de decese din cauza COVID-19
#ObservatorUpdate: Informațiile orei 11:00 despre coronavirus în România și în lume, transmise de Mădălina Iacob.
Vineri, 20.03.2020, 11:08
Doi bărbaţi, prinşi în flagrant când furau bani dintr-un bancomat, prin producerea unei explozii, într-o localitate din Covasna / Ulterior, a fost prins şi un complice al acestora
Doi bărbaţi, în vârstă de 25, respectiv 38 de ani, au fost prinşi în flagrant, vineri dimineaţă, de poliţişti, în timp ce sustrăgeau bani dintr-un bancomat aflat la parterul unui bloc din localitatea Ozun, judeţul Covasna, prin producerea unei deflagraţii. Ulterior, a fost prins şi un complice al acestora, ei fiind suspectaţi de fapte similare comise în Poiana Braşov şi Sinaia.
Vineri, 20.03.2020, 10:39
Românca ucisă de coronavirus în Italia a fost adusă în secret în țară. Sicriul, escortat de Poliție direct la cimitir
Românca ucisă de coronavirus în Italia a fost repatriată fără știrea autorităților. Se pare că totul s-a petrecut după ce reprezentanți ai ministerului de Externe care au fost contactați de rude ale femeii au spus că acest lucru nu le intră în atribuții.
Vineri, 20.03.2020, 10:18